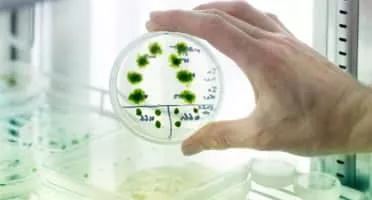

About Plant Breeding
Plant breeding is the science of changing the traits of plants in order to produce desired characteristics. It has been used to improve the quality of nutrition in products for humans and animals.
Peas that don't taste like peas could help the planet

... It is being led by a Belfast-based Plant Breeding company, Germinal...
Commercial development of gene-edited food now legal in England

... But in the UK, it has a staff of 90 who are involved in traditional Plant Breeding...
The high-tech weeding machines cutting herbicide use

... " Some weeds evolve to look more like the crop and they can be harder to find, " says Michael Gore, a professor at the SIPS Plant Breeding and Genetics Section at Cornell University...
Climate change: Could centuries-old wheat help feed the planet?

... He explains that this could be done through traditional Plant Breeding, genetic modification or gene editing - a technique where genes can be very precisely added, removed or replaced...
Plant disease: UK limited olive tree to stop imports of infection

... Some of the operators in the Plant Breeding industry say is the meaning of the restrictions, a ban on the practice, with consequences for the gardener...